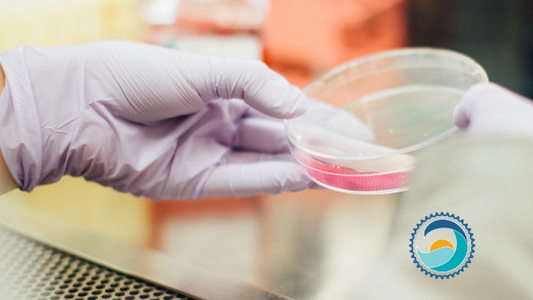

Dive Deeper
Biodegradable Shampoo: The Inside Scoop on Reef...
" I was so proud of my first formula for Stream2Sea—a biodegradable shampoo with all natural, Whole Foods and EcoCert compliant ingredients.I’d thoroughly checked the safety information, carefully avoiding the...
Biodegradable Shampoo: The Inside Scoop on Reef...
" I was so proud of my first formula for Stream2Sea—a biodegradable shampoo with all natural, Whole Foods and EcoCert compliant ingredients.I’d thoroughly checked the safety information, carefully avoiding the...

Empowered Women Empower Women
When do you feel the most empowered? Is it when you’re excelling at what you do and achieving great accomplishments? Or is it when you’re learning from and sharing ideas...
Empowered Women Empower Women
When do you feel the most empowered? Is it when you’re excelling at what you do and achieving great accomplishments? Or is it when you’re learning from and sharing ideas...

What Cruisers Need to Know About Traveling Green
We often talk about eco-awareness among divers, because the whole concept of Stream2Sea’s reef-safer products was developed by a diving fanatic. But there are plenty of other places and activities...
What Cruisers Need to Know About Traveling Green
We often talk about eco-awareness among divers, because the whole concept of Stream2Sea’s reef-safer products was developed by a diving fanatic. But there are plenty of other places and activities...
Nanoparticles Dangerous for People, Oceans
Nanoparticles Dangerous for People, Oceans Non-Nano Titanium Tested Safer Even for Vulnerable Coral Larva [src="https://cdn.shopify.com/s/files/1/0628/4666/4875/files/B20-Blog-Banner.png" force_ On Friday, a customer sent us a copy of an article questioning the safety...
Nanoparticles Dangerous for People, Oceans
Nanoparticles Dangerous for People, Oceans Non-Nano Titanium Tested Safer Even for Vulnerable Coral Larva [src="https://cdn.shopify.com/s/files/1/0628/4666/4875/files/B20-Blog-Banner.png" force_ On Friday, a customer sent us a copy of an article questioning the safety...

Condition Yourself to Avoid Diver Hair
Every ingredient in our leave-in conditioner has been tested to be safe on sea life, so you can actually use it both before and after you get in the water.
Condition Yourself to Avoid Diver Hair
Every ingredient in our leave-in conditioner has been tested to be safe on sea life, so you can actually use it both before and after you get in the water.

Packaging of the Future
With new packaging technology, it is time more companies move away from non-biodegradable plastics.
Packaging of the Future
With new packaging technology, it is time more companies move away from non-biodegradable plastics.